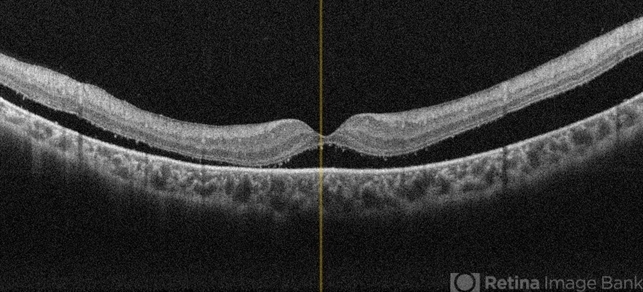

-
 By Tejaswita Verma
By Tejaswita Verma
Retina Foundation hospital(Ahmedabad)
Co-author(s): DR. MANISH NAGPAL,RETINA FOUNDATION,AHMEDABAD - Uploaded on May 22, 2024.
- Last modified by Joshua Friedman on May 22, 2024.
- Rating
- Appears in
- Miscellaneous
- Condition/keywords
- OCT, left eye, subclinical detachment, retinitis pigmentosa
- Photographer
- DR. TEJASWITA VERMA
- Imaging device
-
Scanning laser ophthalmoscope
MIRANTE - Description
- OCT of a 6 year old male child showing subretinal fluid with macula off in a case of subclinical RD in retinitis pigmentosa.

Initializing download.
Initializing download.








---thumb.jpg/image-square;max$79,0.ImageHandler)

